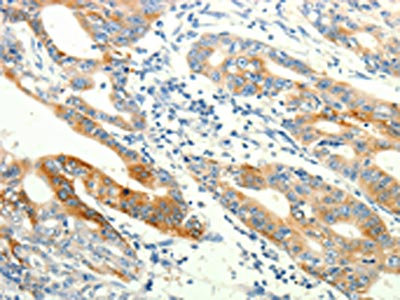

TRPA1 Antibody
-
中文名稱:TRPA1兔多克隆抗體
-
貨號:CSB-PA912872
-
規(guī)格:¥1100
-
圖片:
-
The image on the left is immunohistochemistry of paraffin-embedded Human gastic cancer tissue using CSB-PA912872(TRPA1 Antibody) at dilution 1/60, on the right is treated with synthetic peptide. (Original magnification: ×200)
-
The image on the left is immunohistochemistry of paraffin-embedded Human lung cancer tissue using CSB-PA912872(TRPA1 Antibody) at dilution 1/60, on the right is treated with synthetic peptide. (Original magnification: ×200)
-
-
其他:
產(chǎn)品詳情
-
Uniprot No.:
-
基因名:TRPA1
-
別名:ANKTM 1 antibody; ANKTM1 antibody; Ankyrin-like with transmembrane domains protein 1 antibody; Transformation sensitive protein p120 antibody; Transformation-sensitive protein p120 antibody; Transient receptor potential cation channel subfamily A member 1 antibody; TRPA 1 antibody; Trpa1 antibody; TRPA1_HUMAN antibody
-
宿主:Rabbit
-
反應(yīng)種屬:Human
-
免疫原:Synthetic peptide of Human TRPA1
-
免疫原種屬:Homo sapiens (Human)
-
標(biāo)記方式:Non-conjugated
-
抗體亞型:IgG
-
純化方式:Antigen affinity purification
-
濃度:It differs from different batches. Please contact us to confirm it.
-
保存緩沖液:-20°C, pH7.4 PBS, 0.05% NaN3, 40% Glycerol
-
產(chǎn)品提供形式:Liquid
-
應(yīng)用范圍:ELISA,IHC
-
推薦稀釋比:
Application Recommended Dilution ELISA 1:2000-1:5000 IHC 1:25-1:100 -
Protocols:
-
儲存條件:Upon receipt, store at -20°C or -80°C. Avoid repeated freeze.
-
貨期:Basically, we can dispatch the products out in 1-3 working days after receiving your orders. Delivery time maybe differs from different purchasing way or location, please kindly consult your local distributors for specific delivery time.
-
用途:For Research Use Only. Not for use in diagnostic or therapeutic procedures.
相關(guān)產(chǎn)品
靶點詳情
-
功能:Receptor-activated non-selective cation channel involved in pain detection and possibly also in cold perception, oxygen concentration perception, cough, itch, and inner ear function. Shows 8-fold preference for divalent over monovalent cations. Has a central role in the pain response to endogenous inflammatory mediators and to a diverse array of irritants, such as allylthiocyanate (AITC) from mustard oil or wasabi, cinnamaldehyde, diallyl disulfide (DADS) from garlic, and acrolein, an irritant from tears gas and vehicule exhaust fumes. Acts also as an ionotropic cannabinoid receptor by being activated by delta(9)-tetrahydrocannabinol (THC), the psychoactive component of marijuana. Is activated by a large variety of structurally unrelated electrophilic and non-electrophilic chemical compounds. Electrophilic ligands activate TRPA1 by interacting with critical N-terminal Cys residues in a covalent manner, whereas mechanisms of non-electrophilic ligands are not well determined. May be a component for the mechanosensitive transduction channel of hair cells in inner ear, thereby participating in the perception of sounds. Probably operated by a phosphatidylinositol second messenger system.
-
基因功能參考文獻(xiàn):
- these results identify a novel AKAP-mediated biochemical mechanism that increases TRPA1 sensitivity in peripheral sensory neurons, and likely contributes to persistent mechanical hypersensitivity. PMID: 28500286
- Our findings demonstrate that TRPA1 is a substrate of Cdk5 and that Cdk5 activity is also able to modulate TRPA1 agonist-induced calcium influx and chemo-nociceptive behavioral responses. PMID: 29352128
- TRPA1 Modulating C14 Polyacetylenes from the Iranian Endemic Plant Echinophora platyloba. PMID: 30018233
- LPS caused the increased functional expression of TRPA1, the activation of which involved in LPS-reduced inflammatory responses in primary human OA-FLS, and the inhibition of TRPA1 produces protective effect in LPS-induced arthritis. PMID: 29318481
- Blocking prolyl hydroxylation reveals TRPA1 sensitization to reactive oxygen species (ROS), which enables TRPA1 to convert ROS signalling into cold sensitivity. PMID: 27628562
- Data indicate a variant in the transient receptor potential ankyrin A1 channel (TRPA1) gene that selectively cosegregated with cramp-fasciculation syndrome (CFS) in a father-son pair. PMID: 28436534
- Peripheral neuronal equivalents (PNEs) exhibited morphological, molecular and functional characteristics of sensory neurons and expressed functional TRPA1 channels. PNE treatment with poly I:C caused similar transient heightened responses to TRPA1 activation compared to untreated cells. PMID: 28931666
- These findings provide novel insights into the structure-function relationship of TRPA1 and could lead to the development of more effective analgesics targeted to TRPA1. PMID: 27874100
- TRPA1 is involved in nitric oxide-mediated afferent sensory transmission in the clitoris while, in penile erectile tissue, a role for TRPA1 in cholinergic signaling might be assumed. PMID: 28469181
- data suggest that the most strictly conserved N-terminal ARs define the energetics of the TRPA1 channel gate and contribute to chemical-, calcium- and voltage-dependence. PMID: 27345869
- the heat sensing property of TRPA1 is conserved in mammalians, in which TRPA1 may contribute to sensing warmth and uncomfortable heat in addition to noxious cold. PMID: 27349477
- Systemic desensitization through TRPA1 channels by capsazepine and mustard oil - a novel strategy against inflammation and pain. PMID: 27356469
- This study reveals a direct binding event and characterizes the role of TRPA1 ankyrin repeats in regulating FGFR2-driven oncogenic process; a mechanism that is hindered by miRNA-142-3p PMID: 29038531
- The results obtained with dorsal root ganglia neurons from transient receptor potential cation channel, subfamily A, member 1 channels (TRPA1)-/- mice, TRPM8-/- mice, and wild-type mice, using selective antagonists of TRPA1 and TRPM8 channels, as well as HEK293 cells stably expressing human, TRPA1, indicate that responses to cold, are mediated by TRPA1 channels. PMID: 28408328
- TRPA1 gene polymorphisms is associated with childhood asthma PMID: 27779810
- TRPM8, but not TRPA1, was detected in freshly isolated native human odontoblasts at the protein and mRNA levels, suggesting that odontoblasts play an important role in detecting external cold stimulation via TRPM8 in healthy condition. PMID: 28043013
- neuronal effects of vinca alkaloids require the transient receptor potential ankyrin-1 (TrpA1) channel, and the hypersensitization to painful stimuli in response to the acute exposure to vinca alkaloids is reduced in TrpA1 mutant flies and mice. These findings demonstrate the direct excitation of sensory neurons by CIPN-causing chemotherapy drugs, and identify TrpA1 as an important target during the pathogenesis of CIPN PMID: 29084244
- The TRPA1 cation channel was found to be functionally expressed in primary human osteoarthritis chondrocytes, which is an original finding PMID: 27515912
- The findings of this study support the notion that epigenetic regulation of TRPA1 seems to regulate thermal and mechanical pain sensitivities. PMID: 28030472
- We provided evidence for the extraneuronal presence and upregulation of the proinflammatory TRPA1 receptor in buccal samples of patients with OLP. This may implicate the ion channel in the pathomechanism of OLP. PMID: 27718297
- TRPA1 DNA methylation in whole blood cells are associated with pain symptoms in chronic pain patients. PMID: 26849948
- Here we highlight the role of TRPA1 as a multipurpose sensor of harmful signals and as a sensor of stress and tissue damage. PMID: 27079970
- Three negatively charged amino acids near the outer pore vestibule are involved in heat-evoked TRPA1 activation in the presence of extracellular calcium. PMID: 28194754
- These results suggest that IL-1alpha enhances the translocation of TRPA1 to the plasma membrane via the activation of Erk in A549. PMID: 28629997
- Respiratory syncytial virus and measles virus infection upregulates TRPA1 expression in bronchial epithelial cells. PMID: 28187208
- Protein kinase A is an important kinase acting downstream of inflammatory mediators to cause sensitization of TRPA1. PMID: 28076424
- TRPA1 channels are involved in regulating the extent of airway inflammation driven by cystic fibrosis bronchial epithelial cells. PMID: 27281024
- The aspartate residue at position 915 represents a constriction site of the TRPA1 pore. PMID: 27824920
- data suggest that cardamonin is a selective TRPA1 antagonist, providing novel insight into the target of its anti-nociceptive activity. PMID: 27589700
- TRPA1 activation stimulates a cholinergic mechanism in a tetrodotoxin-resistant manner to cause muscle contraction. PMID: 26928772
- Taken together, these data demonstrated that TRPA1 activation played an important role in the enhanced production of reactive oxygen species induced by cold stress in A549 cell. PMID: 26634370
- Report activation of TRPA1 by o-chlorobenzylidene malononitrile as model of neuropathic pain. PMID: 26046936
- TRPA1 was expressed in all studied regions (tongue, epiglottis, and pharynx), but was always localized below the basal lamina. No immunoreactivity for TRPA1 was found on epithelial cells. PMID: 26530852
- exposure to cigarette smoke extract initially causes an increase in the extracellular level of ROS, which in turn activates lung epithelial TRPA1 PMID: 26504357
- Certain TRPA1 variants and tyrosine-to-phenylalanine mutants exhibited good function compared with non-mutated TRPA1 in transfected HEK293 cells PMID: 26330615
- the inflammatory cytokine TNF-a can modulate the activity of the mechanosensitive ion channels TRPA1 and TRPV4 in odontoblasts via the p38 MAPK pathway but has differential effects on their expression. PMID: 26358221
- TRPA1 activity may modulate asthma, particularly among individuals living in locations prone to high levels of air pollution. PMID: 26039217
- The TRPA1 channel mediates the analgesic action of dipyrone and pyrazolone derivatives PMID: 25765567
- Authors propose that inter-subunit salt bridges between adjacent S4-S5 regions are crucial for stabilizing the conformations associated with chemically and voltage-induced gating of the TRPA1 ion channel. PMID: 25724085
- It appears that TRPA1 channels may be determinants of airway smooth muscle (ASM) contractility and local inflammation control, positioning them as part of novel mechanisms that control (patho)physiological function of airways and ASM. [Review] PMID: 25654580
- Hypothermia mediates its effects on monocytes through TRPA1. PMID: 26054320
- The TRPA1 promoter was hypermethylated in individuals with lower pain thresholds, and promoter DNA methylation can downregulate gene expression. PMID: 24496475
- carnosol is a new anti-nociceptive agent targeting TRPA1 that can be used to explore further biological role in pain therapy. PMID: 25405290
- TRPA1 mrna was increased in the epidermis of itching burn scar patients. PMID: 24695993
- Peptide derived from C-terminus of human TRPA1 channel has a strong interaction and affinity with membranes containing anionic lipids. PMID: 25687973
- findings indicate that transient receptor potential cationic channel type A1 might be involved in afferent neurotransmission in the vagina and work synergistically together with the nitric oxide/cyclic guanosine monophosphate pathway. PMID: 25056810
- Localized TRPA1 channel Ca2+ signals stimulated by reactive oxygen species promote cerebral artery dilation. PMID: 25564678
- TRPM8 and TRPA1 assays were inhibited by probenecid. PMID: 24975826
- TRPA1 is a major mediator of the proinflammatory/proalgesic actions of aromatase inhibitors PMID: 25484020
- TRPA1 is upregulated in colitis and its activation exerts protective roles by decreasing the expressions of several proinflammatory neuropeptides, cytokines and chemokines PMID: 25265225
顯示更多
收起更多
-
相關(guān)疾病:Episodic pain syndrome, familial, 1 (FEPS1)
-
亞細(xì)胞定位:Cell membrane; Multi-pass membrane protein.
-
蛋白家族:Transient receptor (TC 1.A.4) family
-
組織特異性:Expressed at very low level in human fibroblasts and at a moderate level in liposarcoma cells.
-
數(shù)據(jù)庫鏈接:
Most popular with customers
-
-
Phospho-YAP1 (S127) Recombinant Monoclonal Antibody
Applications: ELISA, WB, IHC
Species Reactivity: Human
-
-
-
-
-
-